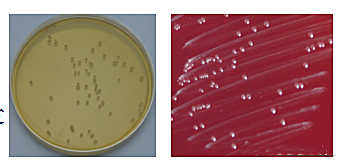
�DƬ
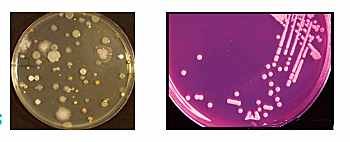
�DƬ

1、什么是微生物?
所謂微生物是指個體微小,必須借助于顯微鏡才能看清它們外形的一群低等的、原始的微小生物,如細菌。
2、微生物特點
·微生物是結構簡單、繁殖快、分布廣、個體最小的生物;
·結構簡單:微生物多數是單細胞,有的具有細胞構造,有的甚至沒有細胞構造;
·生長旺,繁殖快(大腸桿菌在它的適宜37-44℃之間,20-30分鐘繁殖一代);
·分布廣.種類多(10萬多種) :自然界中到處都有,如水、空氣、土壤等;
·個體小:小于0.1mm,肉眼不可見;
·適應性強,易變異;
·代謝強,轉化快。
3、微生物分類
·真核細胞型微生物——細胞核分化程度高,有核膜和核仁,細胞器完整。如真菌。
·原核細胞型微生物——細胞核的分化較低,僅有原始核,無核膜、核仁。細胞器很不完善。DNA和RNA同時存在。這類微生物眾多,有細菌、放線菌、支原體、衣原體、立克次體、螺旋體。
·非細胞型微生物——是最小的微生物一類微生物。無典型的細胞結構,只能在活細胞內生長繁殖。核酸類型為DNA或RNA。病毒屬之。

4、微生物實驗室常規儀器設備
·電子天平:0.1g;0.01g;
·pH計;
·加熱裝置:電爐、微波爐;
·高壓滅菌鍋
·高壓鍋滅菌檢測產品
1、壓力滅菌指示卡(121℃);
2、生物指示劑(121℃,15min )
·干燥滅菌箱
·水浴鍋

·超凈工作臺/生物安全柜
(1)區別:保護對象不同


·操作臺內的滅菌設備
*酒精燈;
*紅外線滅菌器;
*電子火焰滅菌器;
·培養箱
*一般恒溫培養箱;
*厭氧培養箱(厭氧培養罐)
二、微生物檢測
1、常用標準
GB 4789.2-2016 食品安全國家標準 食品微生物學檢驗 菌落總數測定;
GB 4789.3-2016 食品安全國家標準 食品微生物學檢驗 大腸菌群計數;
GB 4789.15-2016 食品安全國家標準 食品微生物學檢驗 霉菌和酵母計數;
GB 4789.4-2016 食品安全國家標準 食品微生物學檢驗 沙門氏菌檢驗;
GB 4789.10-2016 食品安全國家標準 食品微生物學檢驗 金黃色葡萄球菌檢驗;
GB 4789.30-2016 單核細胞增生李斯特氏菌檢驗;
2、菌落總數測定
菌落總數(aerobic plate count)
食品檢樣經過處理,在一定條件下(如培養基、培養溫度和培養時間等)培養后,所得每mL(g)檢樣中形成的微生物菌落總數。

衛生學意義:
·食品的菌落總數嚴重超標,說明其產品的衛生狀況達不到基本的衛生要求。
·加工、貯存運輸過程中是否受到污染——衛生質量
·衛生學指標:菌落總數和致病菌有本質區別,必須配合其他病原菌項目的檢驗,才能作出比較全面準確的評定。

計數和報告-結果報告

注意事項:
★必須做空白對照:監測培養基、平皿、稀釋液的無菌程度。同時,應在工作臺內打開一塊空白PCA(其暴露時間應與檢樣時間相當),以了解樣品在檢驗過程中有無受到來自環境的污染。
★水浴和傾注溫度:46℃±1℃。
★培養條件:一般樣品36℃±1℃/48h±2h,水產品(指原生態、未加工水產品)30℃±1℃/72h±3h。
★如樣品(干調、面粉、脫水蔬菜)中可能含有在瓊脂表面蔓延生長的菌落,可在凝固后的瓊脂表面再覆蓋一層(4mL)培養基。
★樣品稀釋液有時會帶有細碎的食物顆粒(如奶粉、堅果),為避免這些顆粒與菌落發生混淆,可將樣品稀釋液與PCA混合,單做培養,置于4℃冰箱放置同樣時間,以便在計數時作為對照。
3、大腸菌群測定
(1)定義:在一定培養條件下能發酵乳糖、產酸產氣的需氧和兼性厭氧革蘭氏陰性無芽胞桿菌。
該菌主要來源于人畜糞便,作為糞便污染指標評價食品的衛生狀況,推斷食品中腸道致病菌污染的可能。
這些細菌在生化及血清學方面并非完全一致。根據進一步的生化鑒定試驗,可將大腸菌群細分為大腸埃希氏菌(俗稱大腸桿菌)、弗氏檸檬酸桿菌、肺炎克雷伯氏菌和陰溝腸桿菌等。
(2)檢驗原理:
MPN法:是統計學和微生物學結合的一種定量檢測法。待測樣品經系列稀釋并培養后,根據其未生長的最低稀釋度與生長的最高稀釋度,應用統計學概率論推算出待測樣品中大腸菌群的最大可能數。
平板計數法:大腸軍群在固體培養基中發酵乳糖產酸,在指示劑的作用下形成可計數的紅色或紫色,帶有或不帶有沉淀環的菌落
4、霉菌酵母計數

培養基的使用:
▲兩種培養基都含有氯霉素,可以抑制細菌的生長;
▲對氯霉素耐藥的一些細菌在這兩種培養基上也會生長,可以通過菌落形態來區分,或者通過染色鏡檢來判定;
▲如果需要分開報告霉菌和酵母菌的數量,主要通過菌落形態來區分。
細菌、酵母菌及霉菌的不同菌落形態:
細菌:由于細胞小,形成的菌落較小,較薄、較透明、且有“細膩感”。可產生不同色素,菌落可呈現五顏六色且形態多樣。
酵母菌:由于細胞較大且不能運動,一般菌落比細菌大、厚且透明度差。產生色素較單一,通常乳白色,少數為橙紅色,個別黑色。
霉菌:菌落形態較大,質地疏松,外觀干燥,不透明,呈現蛛網狀、絨毛狀、棉絮狀或氈狀;菌落與培養基間的聯系緊密,不易挑起,菌落正面與反面、邊緣與中心的顏色和構造常不一致。

細菌、酵母菌及霉菌的鏡檢形態。
細菌:包括三種基本形態,球狀、桿狀和螺旋狀。

酵母菌:細胞通常有球狀、卵圓狀、橢圓狀、柱狀和香腸狀。

霉菌:細胞構造與酵母菌相似,但以菌絲體形式存在。
4、致病菌檢驗



(1)選擇性分離
分別用3mm接種環取增菌液1環,劃線接種于一個BS瓊脂平板和一個XLD瓊脂平板(或HE瓊脂平板或沙門氏菌顯色培養基平板),于36℃±1℃分別培養18h~24h(XLD、HE、顯色培養基)或40h~48h(BS瓊脂平板)
為了最大可能的檢出沙門氏菌,必須使用兩種或以上選擇性分離培養基。

(2)生化鑒定

(3)血清學鑒定
▲血清學作為鑒定的一部分,必須完成;
▲實驗室必須配備沙門氏菌的自凝性、多價菌體(O)和多價鞭毛(H)診斷血清;
▲其中血清學分型為選作試驗項目;
▲血清學試驗必須基于生化試驗的結果,不能單純以血清學實驗結果來報告最終結果。
(4)自凝性檢查及O多價鑒定

三、菌種保藏

1、挑選特征典型的純菌菌落
2、確定保藏的合適菌體形態
3、選擇最適宜的保藏方法
4、定期對保藏菌種進行檢查

磁珠保藏菌種方法:
刮取新鮮純培養物,配置3-4麥氏濁度的菌懸液。
加入到保存管中,擰緊,來回顛倒4-5次,磁珠會吸附菌體,然后將培養液吸取干凈置于-20℃或-70℃,或液氮中保存。









當前所在頁面:















